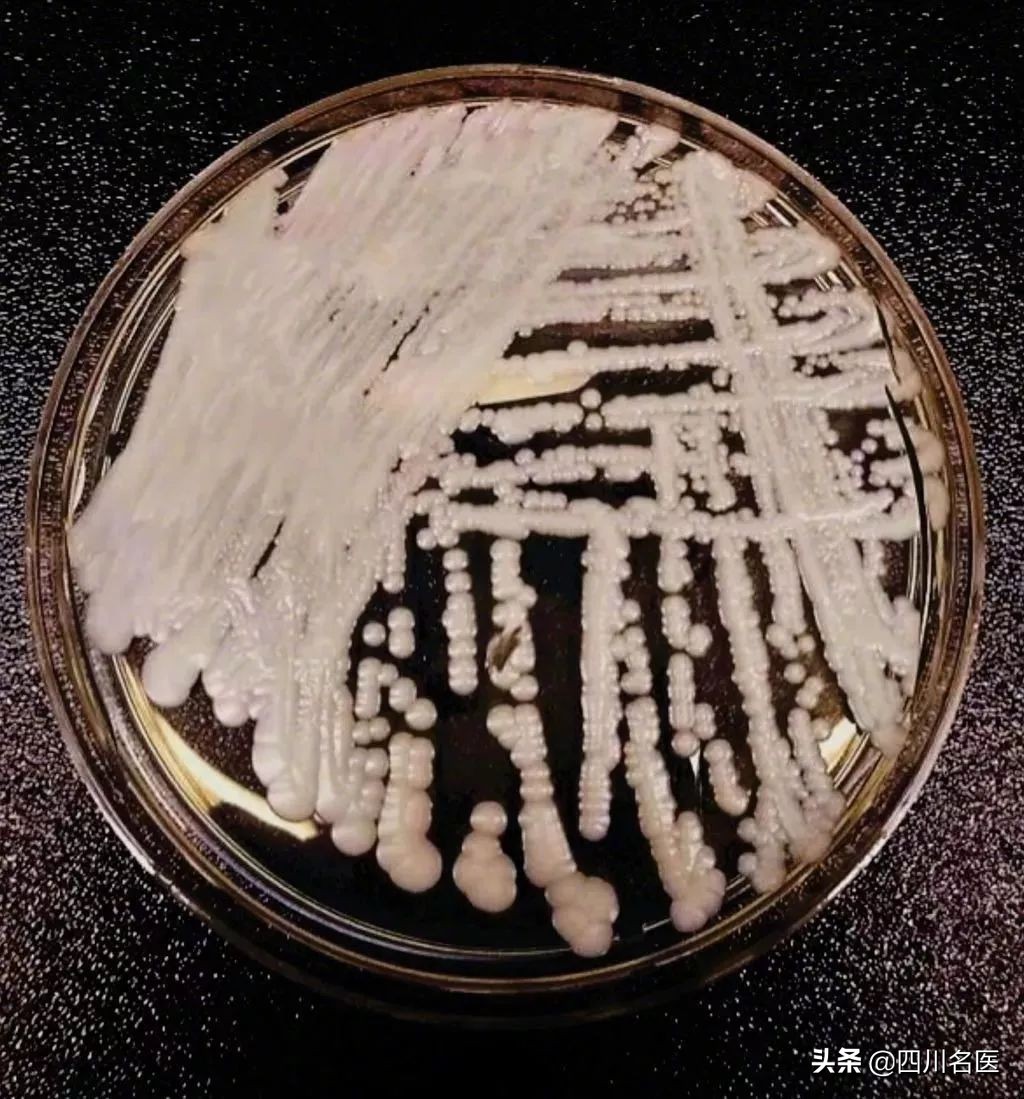
条件性真菌病最常见致病真菌,真菌病分真菌感染和真菌中毒
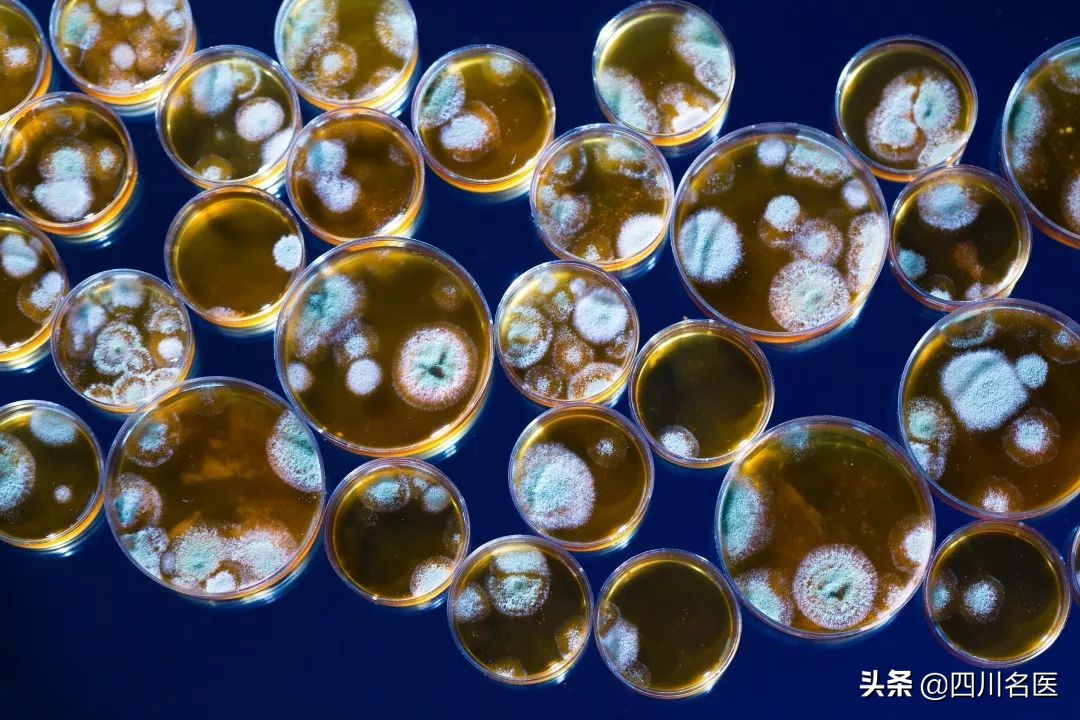
条件性真菌病最常见致病真菌,真菌病分真菌感染和真菌中毒

据CBS新闻报道:一种名为耳念珠菌的多重耐药性真菌近日在美国多地爆发,截至2月底,全美已有587例确诊病例,其中过半的感染者在90天内身亡!美国疾病控制与预防中心已将耳念珠菌列入“紧急威胁”名单。4月8日,中国工程院院士、第二军医大学长征医院皮肤科教授廖万清表示,截至目前,中国已确认18例超级真菌临床感染病例。
据研究,当这种真菌感染人体之后,患者会出现高烧、呼吸衰竭和多器官衰竭,最终导致患者死亡。这种叫耳念珠菌的真菌致死率高达百分之六十,多种抗真菌药物对这种真菌毫无作用,让医生感到非常头痛,因此被称为超级真菌。
小康妹儿看到这个新闻,心中有些疑问:真菌到底是个啥?真菌对人体的危害有多大呢?真菌感染易得吗?如何预防和治疗呢?
小康妹儿今天就来探索一下真菌的世界。
01
真菌离我们有多近?
真菌遍布自然界

真菌是一种真核生物,有细胞核和细胞器,没有叶绿素,基本形态为菌丝和(或)孢子。它们从动物、植物的活体、死体和它们的排泄物,以及断枝、落叶和土壤腐殖质中来吸收和分解其中的有机物,作为自己的营养。
最常见的真菌是各类蕈菌,即香菇、草菇、金针菇、双孢蘑菇、平菇、木耳、银耳、竹荪、羊肚菌等大型真菌。另外真菌也包括霉菌和酵母菌。
一部分真菌既是一类重要的菌类蔬菜,又是食品和制药工业的重要资源。可另一部分却会让人类患上真菌病。
与人类疾病相关的真菌不足200种

真菌病是由真菌引起的疾病。常见的真菌病有湿疹、灰指甲、体癣、脚气以及各类炎症等。
在已记录的5万~25万种真菌中,与人类疾病有关的不足200种。除个别情况外,人类的真菌感染源均来自外在环境,通过吸人、摄人或外伤植入而获得。
真菌病分深浅
真菌病在临床上一般分为浅部真菌病和深部真菌病两大类。浅部真菌病有头癣、体癣、股癣、手癣、足癣、花斑癣、叠瓦癣等;深部真菌病就是皮下组织感染和系统感染。
每年有一百多万人死于真菌感染
真菌感染是我国和全世界范围内临床医学中面临的严重问题。据统计,每年世界上有一百多万人死于真菌感染,常见的单一抗生素已无力抵抗。
真菌多侵犯衰弱者

少数真菌可使正常人致病,大部分则只在特殊条件下致病。
真菌对免疫系统不成熟或受损的人、严重慢性基础病群体最为危险,包括新生儿和老年人、吸烟人群、糖尿病患者以及自身免疫性疾病患者。
02
真菌感染何以横行?
滥用抗生素
使用抗生素,一方面会杀死普通致病菌,但另一方面也可能让部分致病菌的抗药能力得到了“锻炼”,使其变异、升级,成为耐药菌株。
这些原先并不占优势的、具有抗药性的致病菌存留下来后,不仅会成为优势群体,还会将这种耐药本领迅速传播,让越来越多的病原体变成所谓的超级细菌,甚至目前的抗生素都对其束手无策。
据统计,全世界每年约有70万人死于抗药性感染,包括结核病、艾滋病毒和疟疾,而世界卫生组织也表示,若不对抗生素的使用进行干预,若干年后,即使是普通的感染,都会威胁生命!
我国是滥用抗生素的“重灾区”
“美国枪支容易买得到,抗生素很难买得到,而中国恰好相反。”用这句话来形容抗生素在中国的滥用程度再恰当不过了。
数据显示,每年在全世界大约有50%的抗生素被滥用,而中国在这一比例中占了近80%。
尽管近年来抗生素的使用已受到控制,但有专家指出在农村地区,抗生素的使用率惊人,近78.5%的农村居民在感冒时会服用抗生素类药物,而往往他们认为自己吃的是“消炎药”。
▎消炎药 vs 抗生素
在医学上,消炎药通常有两类:一类是可的松、氢化可的松、地塞米松等激素;另一类是布洛芬、阿司匹林、美洛昔康等消炎止痛药。
扛炎药是对抗炎症的,就是减轻红、肿、热、痛等现象。
抗生素一般都会含霉素、西林、环素、沙星、磺胺等字眼,其说明书上也会有“对某某细菌有较好的抗菌作用”字样。

扁桃体炎、鼻窦炎、肺炎、支气管炎、尿路感染等可以使用抗生素;但普通感冒、流感、流行性腮腺炎、水痘、结膜炎等一般不需要抗生素。如果腹痛腹泻就更不需要用抗生素治疗了。
03
如何远离致病微生物的侵害呢?
慎用抗生素
一代耐药菌的产生往往只需要两年,而开发一个新药却需要耗费10年甚至20年,而且再强大的抗生素都有被细菌攻破的可能。因此严格控制抗生素的使用很关键,细菌没有了药物的压力,其耐药的本领也会慢慢消退。
如果生病了,不是必要的话,尽量少用抗生素吧。
提高自身免疫力
平时人体有免疫系统,自身的抗体会监控、识别入侵者。当细菌、病毒接近细胞时,抗体会将自己紧锁在入侵者的“盔甲”上,白细胞发现信号后即会吞噬入侵者。因此提高细胞活力对提高免疫力很重要。
▎饮食注意

日常的膳食中不妨多吃些香菇、木耳、平菇等。
菌菇类富含多种营养元素,18种氨基酸、30多种酶、菌多糖等,不仅能诱导人体产生干扰素,提高机体免疫力,抵抗病毒侵袭,还有较好的辅助抗肿瘤、抗动脉硬化、改善白细胞等能力。
▎卫生注意

美国一项研究显示,人的双手平均携带1000万个细菌,比“细菌*弹炸**”抹布还要多,正确洗手能减少30—50%的疾病!因此学会正确洗手、勤洗手,很重要。
去完超市、商场;打扫完卫生;使用了电脑鼠标;接触了宠物……都要洗手,可用洗手液或肥皂,进行搓洗。
更换被单,鞋袜,勤洗手脚、消毒剪指甲的工具、选用吸汗的袜子和通风的鞋子,都是日常需要注意的避免手足皮肤真菌感染的细节。
▎消毒注意
不小心割伤、划伤,即使伤口不深,也要能够进行消毒。
建议家中常备碘伏,其比酒精消毒范围更广泛,比碘酊对皮肤的刺激性更小,还可在创面上形成一层保护膜,不易让细菌及尘埃再次侵入伤口,安全性更高。
真菌会越变越强。恰巧,我们人类也会。
#今日互动#
你有被真菌感染过吗?
内容来源:有来医生、BTV我是大医生官微、果壳、知乎、新浪微博等
图片来源:123rf、新浪微博
编辑:JR
点在看,科学预防真菌感染~